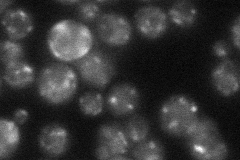
YKR088C
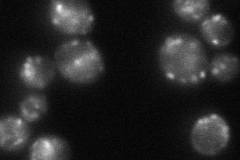
YKR088C
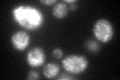
YKR088C
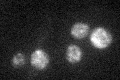
YKR088C

View description
Integral membrane protein localized to late Golgi vesicles along with the v-SNARE Tlg2p; required for asymmetric localization of Kar9p during mitosis; GFP-fusion protein localizes to the cytoplasm in a punctate pattern
Localization:
Intensity:
Fold change:
Significance:
-
C’ GFP library in SD

punctate41.26 -
N' NOP1pr-GFP in SD

punctate113.613 -
N' TEF2pr-mCherry in SD

punctate216.081 -
N' NATIVEpr-GFP in SD
punctate35.6464 -
N' TEF2pr-VC and Cyto-VN in SD
punctate63.3782 -
C’ GFP library in SD+DTT
punctate43.591.05No -
C’ GFP library in SD+H2O2

punctate32.670.79No -
C’ GFP library in Starvation Media
punctate31.780.77No -
C’ GFP library on the background of Pup2-DaMP

punctate -
C’ GFP library on the background of CCT mutant

punctate34.93540.846478No
